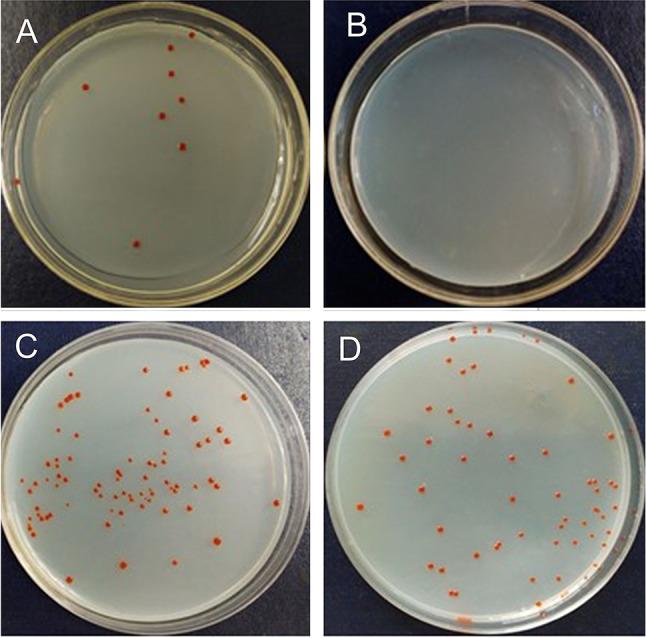
https://cdn.ncbi.nlm.nih.gov/pmc/blobs/3703/10449756/2ae693ea63f5/42995_2023_187_Fig7_HTML.jpg

短链脂肪酸(SCFAs)作为潜在的复苏因子,可促进海洋沉积物中未培养细菌的分离和培养。
Short-chain fatty acids (SCFAs) as potential resuscitation factors that promote the isolation and culture of uncultured bacteria in marine sediments.
作者信息
Sun Chun-Shui, Zhou Liu-Yan, Liang Qi-Yun, Wang Xiao-Man, Lei Yi-Xuan, Xu Zhen-Xing, Wang Feng-Qing, Chen Guan-Jun, Du Zong-Jun, Mu Da-Shuai
机构信息
Marine College, Shandong University, Weihai, 264209 China.
State Key Laboratory of Microbial Technology, Institute of Microbial Technology, Shandong University, Qingdao, 266237 China.
出版信息
Mar Life Sci Technol. 2023 Jul 29;5(3):400-414. doi: 10.1007/s42995-023-00187-w. eCollection 2023 Aug.
UNLABELLED
Many marine bacteria are difficult to culture because they are dormant, rare or found in low-abundances. Enrichment culturing has been widely tested as an important strategy to isolate rare or dormant microbes. However, many more mechanisms remain uncertain. Here, based on 16S rRNA gene high-throughput sequencing and metabolomics technology, it was found that the short-chain fatty acids (SCFAs) in metabolites were significantly correlated with uncultured bacterial groups during enrichment cultures. A pure culture analysis showed that the addition of SCFAs to media also resulted in high efficiency for the isolation of uncultured strains from marine sediments. As a result, 238 strains belonging to 10 phyla, 26 families and 82 species were successfully isolated. Some uncultured rare taxa within and were successfully cultured Amongst the newly isolated uncultured microbes, most genomes, e.g. bacteria, possess SCFA oxidative degradation genes, and these features might aid these microbes in better adapting to the culture media. A further resuscitation analysis of a viable but non-culturable (VBNC) strain verified that the addition of SCFAs could break the dormancy of in 5 days, and the growth curve test showed that the SCFAs could shorten the lag phase and increase the growth rate. Overall, this study provides new insights into SCFAs, which were first studied as resuscitation factors in uncultured marine bacteria. Thus, this study can help improve the utilisation and excavation of marine microbial resources, especially for the most-wanted or key players.
SUPPLEMENTARY INFORMATION
The online version contains supplementary material available at 10.1007/s42995-023-00187-w.
未标注
许多海洋细菌难以培养,因为它们处于休眠状态、数量稀少或丰度较低。富集培养作为分离稀有或休眠微生物的重要策略已得到广泛测试。然而,更多机制仍不明确。在此,基于16S rRNA基因高通量测序和代谢组学技术,研究发现富集培养过程中代谢产物中的短链脂肪酸(SCFAs)与未培养细菌类群显著相关。纯培养分析表明,向培养基中添加SCFAs也能高效地从海洋沉积物中分离未培养菌株。结果,成功分离出238株菌株,分属于10个门、26个科和82个种。在[具体分类单元1]和[具体分类单元2]中的一些未培养稀有分类单元被成功培养。在新分离的未培养微生物中,大多数基因组(如细菌)拥有SCFA氧化降解基因,这些特征可能有助于这些微生物更好地适应培养基。对一株活的但不可培养(VBNC)的[菌株名称]进行的进一步复苏分析证实,添加SCFAs可在5天内打破[菌株名称]的休眠,生长曲线测试表明SCFAs可缩短延迟期并提高生长速率。总体而言,本研究为SCFAs提供了新的见解,SCFAs首次作为未培养海洋细菌的复苏因子进行研究。因此,本研究有助于提高海洋微生物资源的利用和挖掘,特别是对于最需要的或关键的微生物。
补充信息
在线版本包含可在10.1007/s42995-023-00187-w获取的补充材料。